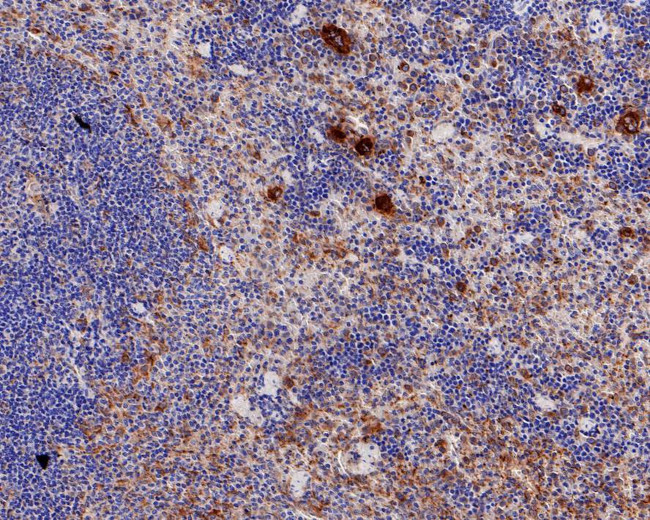
TGF beta-1 Antibody in Immunohistochemistry (Paraffin) (IHC (P))

Search
Invitrogen
TGF beta-1 Recombinant Rabbit Monoclonal Antibody (PD00-17)
{{$productOrderCtrl.translations['antibody.pdp.commerceCard.promotion.promotions']}}
{{$productOrderCtrl.translations['antibody.pdp.commerceCard.promotion.viewpromo']}}
{{$productOrderCtrl.translations['antibody.pdp.commerceCard.promotion.promocode']}}: {{promo.promoCode}} {{promo.promoTitle}} {{promo.promoDescription}}. {{$productOrderCtrl.translations['antibody.pdp.commerceCard.promotion.learnmore']}}
图: 1 / 3
TGF beta-1 Antibody (MA5-50685) in IHC (P)



Please note: We are reviewing Western blot images included in the antibody testing data in our catalog, including those provided by third parties. Unless expressly labeled or annotated as “raw-unedited”, Western blot images included in the antibody testing data in our catalog may have been edited, optimized or otherwise adjusted for presentation.
产品信息
MA5-50685
种属反应
宿主/亚型
Expression System
分类
类型
克隆号
抗原
偶联物
形式
浓度
规格
纯化类型
保存液
内含物
保存条件
运输条件
RRID
产品详细信息
Positive control: Raji cell lysate, K-562 cell lysate, mouse spleen tissue lysate, rat spleen tissue lysate, rat spleen tissue, mouse spleen tissue.
Predicted band size: 44 kDa
Subcellular Location: Extracellular matrix, Secreted.
靶标信息
TGF beta-1 (TGFB1, Transforming Growth Factor Beta 1) is a polypeptide member of the transforming growth factor beta superfamily of cytokines, found almost ubiquitously in tissues. Transforming growth factor (TGF)-b is stored in the extracellular matrix as a latent complex with its pro-domain. Activation of TGF beta-1 requires the binding of aV integrin to an RGD sequence in the prodomain and exertion of force on this domain, which is held in the extracellular matrix by latent TGF-b binding proteins. Latent forms are complexes of TGF beta-1, an amino-terminal portion of the TGF-beta precursor, designated TGF-LAP (TGF-latency associated peptide), and a specific binding protein, known as LTBP. TGF beta-1 helps regulates proliferation, differentiation, adhesion, migration in many cell types. Many cells have TGF beta receptors, and the protein positively and negatively regulates many other growth factors. TGF beta-1 is cleaved into a latency-associated peptide and a mature TGF beta-1 peptide, and is found in either a latent form composed of a TGFB1 homodimer, a LAP homodimer, and a latent TGFB1-binding protein, or in an active form composed of a TGF beta-1 homodimer. The mature peptide may also form heterodimers with other TGF beta family members. The gene for TGF beta-1 is frequently upregulated in tumor cells, and mutations in this gene result in Camurati-Engelmann disease and cystic fibrosis.
仅用于科研。不用于诊断过程。未经明确授权不得转售。
篇参考文献 (0)
生物信息学
蛋白别名: regulatory protein; TGF b; TGF b 1; TGF beta; tgf beta 1; TGF beta-1; TGF beta-1 protein; tgf beta1; TGF β; TGF β 1; TGF β1; TGF-B1; TGF-beta 1; TGF-beta 1 protein; TGF-beta-1; TGFβ1; Transforming growth factor; transforming growth factor b1; transforming growth factor beta; transforming growth factor beta-1; Transforming growth factor beta-1 proprotein; transforming growth factor β1; transforming growth factor, beta-1; transforming growth factor-beta 1
基因别名: TGF-beta1; TGFB; Tgfb-1; TGFB1; TGFbeta1
UniProt ID: (Rat) P17246, (Mouse) P04202
Entrez Gene ID: (Rat) 59086, (Mouse) 21803